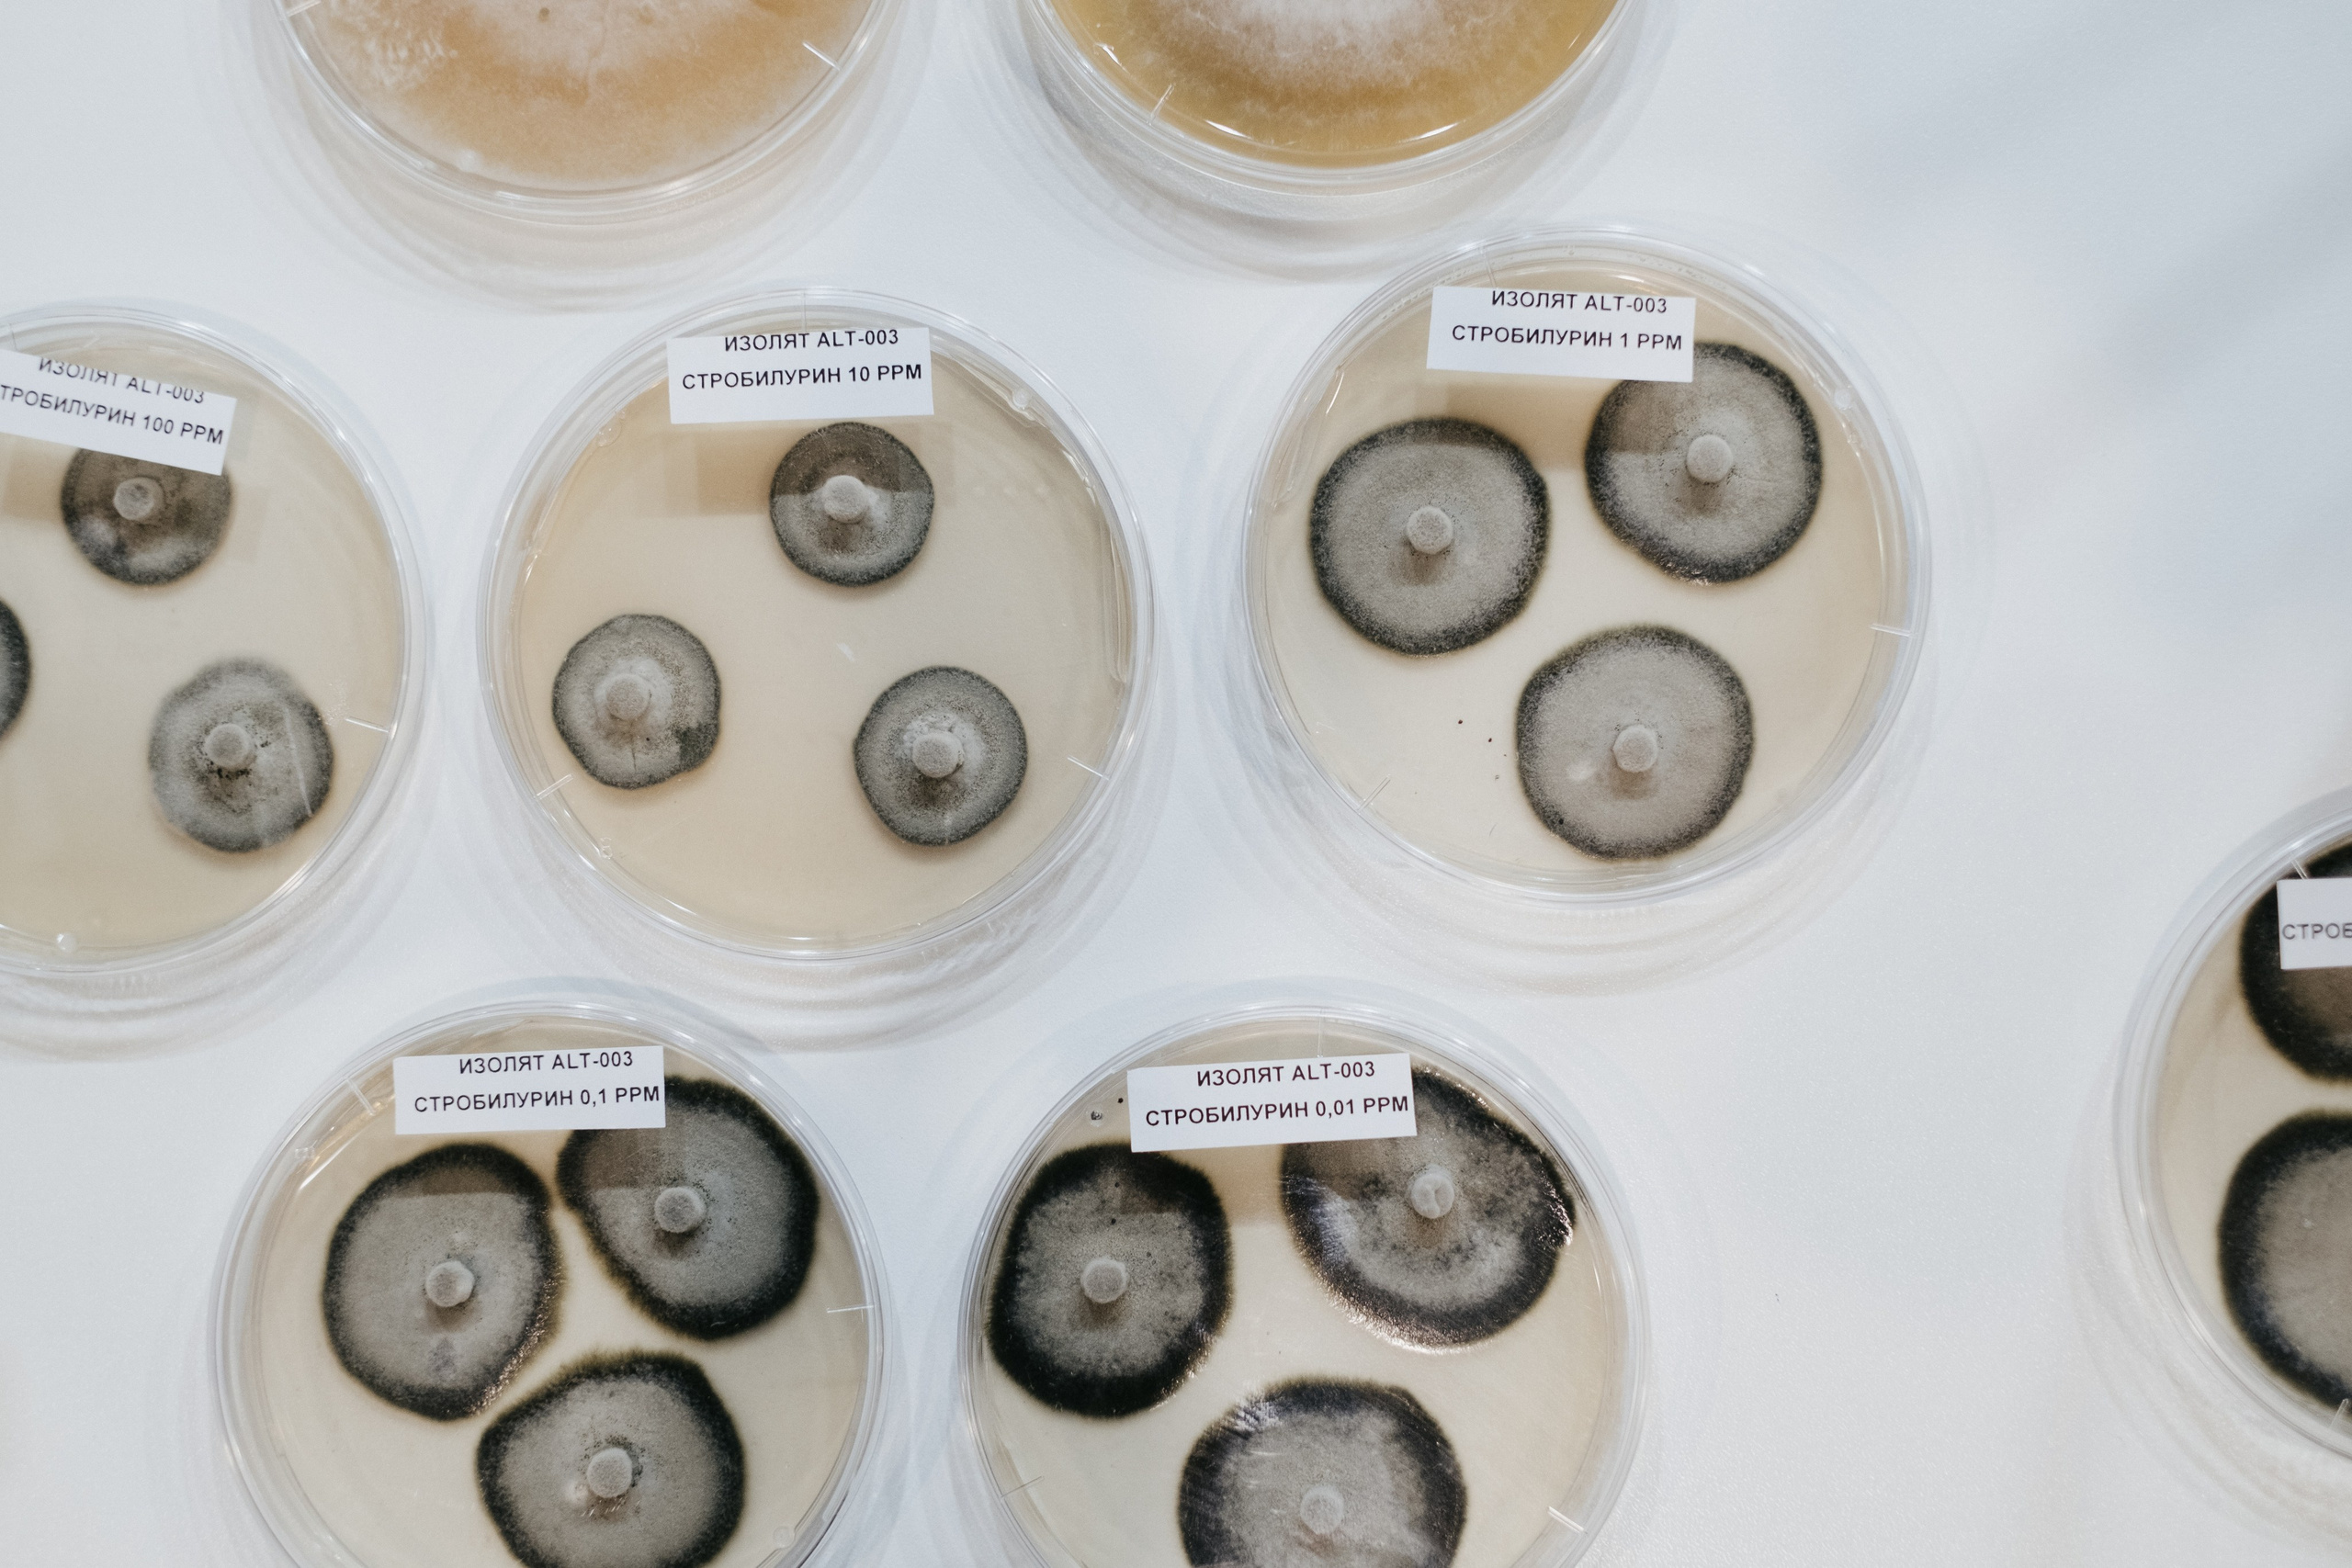
Выставка Fruit Trade: Сады и&nbsp;Виноградники в&nbsp;Краснодаре 18–19&nbsp;февраля 2025 года на&nbsp;площадке Экспоград-Юг

Выставка Fruit Trade: Сады и Виноградники
Фотоотчет с международной выставки Fruit Trade: Сады и Виноградники 18–19 февраля 2025 года проходящая в ВКК «Экспоград Юг», Конгрессная ул., 1, Краснодар
Фотоотчет с международной выставки Fruit Trade: Сады и Виноградники 18–19 февраля 2025 года проходящая в ВКК «Экспоград Юг», Конгрессная ул., 1, Краснодар